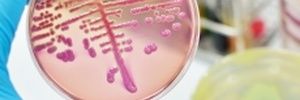

Древняя традиционная медицина основывалась на главном принципе ближе к природе!
Древние лекари в качестве лекарственных средств широко использовали лечебные свойства плодов, ягод, фруктов, овощей, растений.
Траволечение
Русский человек с незапамятных времен лечится травами, как и сейчас. Если у нас заболела голова или горло, мучает приступ кашля, поднялась температура, нелады с кишечником, мы в первую очередь прибегаем к дарам природы. Пьем чай с лимоном при температуре, чай с малиной при простуде, жуем заварку черного чая, завариваем кору граната при поносе.

Общие заболевания
Считается, что нормальное артериальное давление 120/80 мм. рт. столба.Далее это нарушение распространяется на другие органы, связанные с по…

Сердечно-сосудистые
Большинство сердечно-сосудистых заболеваний можно предотвратить путем принятия мер в отношении таких факторов риска, таких как употребление…

Нарушения обмена веществ
Обмен веществ – основополагающая функция организма. Без постоянно происходящих обменных процессов жизнь любого живого существа была бы нево…

Повреждения и заболевания кожи
Кожа — прочная и в то же время хрупкая защита человеческого тела, а ее здоровье является непременным условием хорошего самочувствия.Причин,…

Заболевания органов дыхания
Система органов дыхания состоит из носовых ходов, гортани, трахеи, бронхов, легких и плевры (соединительнотканной оболочки, покрывающей лег…

Аллергия
Аллергия − это хроническое заболевание, вызванное неадекватной, нежелательной и неожиданной реакцией иммунной системы на воздействие вещест…
Инфекционные заболевания
Инфекционные заболевания — группа заболеваний, вызываемых проникновением в организм патогенных микроорганизмов, вирусов и прионов.Одной из …

Мужские заболевания
Мужские заболевания или заболевания мужской половой системы на сегодняшний день являются довольно распространенной проблемой для мужчин сре…

Заболевания мочеполовой системы
Женщины чаще мужчин испытывают симптомы таких урологических заболеваний, как цистит и пиелонефрит, что обусловлено анатомическим строением …

Заболевания нервной системы
Нервная система человека — это сложная и многогранная, отвечающая за множество различных операций, которые мы не задумываясь совершаем кажд…

Уход за кожей и волосами
Осень и зима — довольно сложные периоды для кожи и волос.Основная проблема — высушивание волос, что в дальнейшем приводит к появлению секущ…

Заболевания желудочно-кишечного тракта
Заболевания желудочно-кишечного тракта относятся к числу наиболее часто встречающейся патологии в мире.Мужчин погибает вдвое больше, чем же…